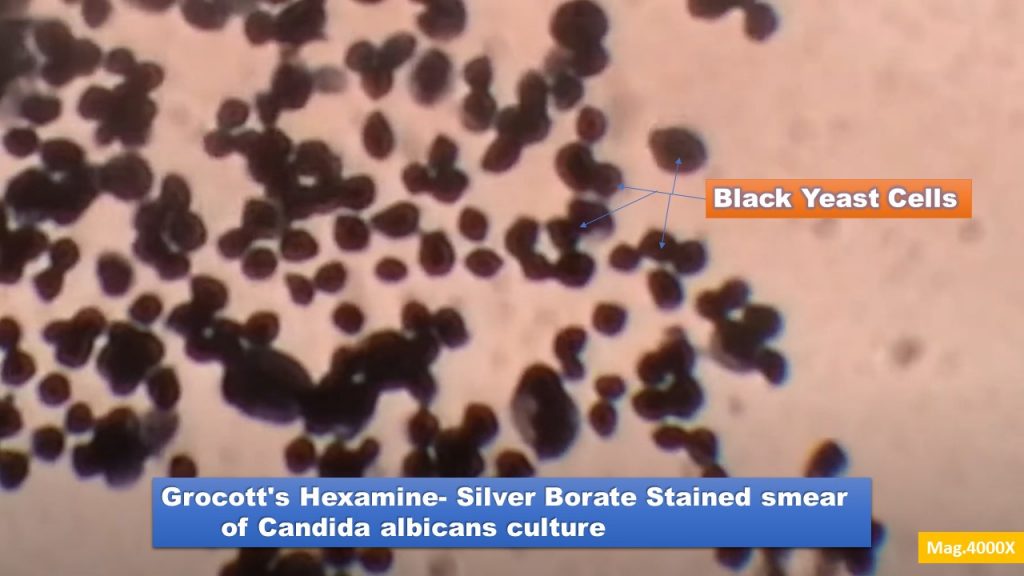
Grocott's Hexamine- Silver Borate Stain: Introduction, Principle, Procedure, Result Interpretation

Grocott’s Hexamine- Silver Borate Stain: Introduction, Principle, Procedure, Result Interpretation
Introduction of Grocott’s Hexamine- Silver Borate Stain
Grocott’s Hexamine-Silver borate stain is the special staining method of choice for a large majority of histopathology laboratories for the demonstration of all fungi.
Principle of Grocott’s Hexamine- Silver Borate Stain
The exposure of formalin-fixed sections or methanol treated sputum is to chromic acid that reacts with fungal cell wall polysaccharide components to form chromic acid-aldehydes. A hexamine-silver solution at an alkaline pH reduces them and this causes fungal structures to be selectively blackened
Requirements for Grocott’s Hexamine- Silver Borate Stain
Equipment and reagents required for staining are as follows-
- Coplin jars
- Dropping bottles
- Coverslips
- Dissecting needles, forces, scalpels, etc.
- Ordinary filter papers
- Mounting media (DPX or Canada balsam mountant)
- Slide washing tray
- Methanol ( in the case of sputum)
- 5% chromic acid
- Sodium metabisulfite
- Distilled water (D/W)
- hexamine solution ( incubating solution)
- 0.1 % aqueous gold chloride
- 3% sodium thiosulphate
- 0.2% light green in 0.2% acetic acid
- Microscope
Reagent preparation of Grocott’s Hexamine-Silver borate stain
- 15% sodium tetraborate ( borax) in D/W
- Methenamine silver
5% silver nitrate in D/W- 5ml
3% Methenamine in D/W- 100ml
Add Silver nitrate to methenamine solution, gently shaking until precipitate dissolves. The mixture will keep for 1-2 months at 4°C. - Incubating solution ( Working solution)
Borax ( solution 1): 5ml
D/W: 25 ml
Methenamine silver (Solution 2)): 25 ml
Ideally, solutions a,b, and D/W should be preheated to 56° C and mixed prior to use. As silver the solution starts degenerates, borax is added.
- % aqueous chromic acid (chromium trioxide)
- 1% aqueous sodium metabisulphite
- 5% sodium thiosulphate
- 1% aqueous gold chloride
- 2% light green in 0.2% acetic acid
The procedure of Grocott’s Hexamine- Silver Borate Stain
- Take sections to water or if sputum fixes smear of sputum with methanol.
- Oxidize in 5% chromic acid (Chromium – tetraoxide) for 1 hour.
- Wash well in tap water.
- Rinse in 15 sodium meta bisulfate.
- Wash in tap water for 5 minutes.
- Rinse in D/W then place preheated (56° C) silver incubating solution in a dark place for 20-30 minutes. Note: Check control sections for dark brown fungus; if not, return to solution and check at 3-minute intervals until the right color is reached.
- Rinse well in D/W.
- Treat in 0.1 % aqueous gold chloride for 4 minutes.
- Rinse in D/W.
- Place in 3% sodium thiosulphate for 5 minutes.
- Counter strain with 0.2% light green in 0.2% acetic acid for 1 minute.
- Blot dehydrate clear and mount.
Result Interpretation of Grocott’s Hexamine- Silver Borate Stain
Fungal elements: Black
Other oxidizable carbohydrates, including glycogen: Black
Background: Green
Keynotes on Grocott’s Hexamine- Silver Borate Stain
- Keep the stock hexamine-silver solution at 4°C and out of direct sunlight. It will last 1-2 months in the refrigerator. Give it a thorough shake if a white precipitate forms; it should disperse.
- Extending the period in chromic acid too long will cause the carbohydrates to oxidize to carboxylic acid, preventing the silver stain from being taken
- If your sections have a lot of silver precipitates, it’s probably because you used low-grade
- Other oxidizable carbohydrates, including glycogen, may take this stain black and therefore reporter may have the ability to differentiate fungal structure from other than fungal elements.
Further Reading
- https://skinpathonline.wordpress.com/2011/06/22/grocott-hexamine-silver-special-stain-for-fungus-%E2%80%93-method-and-tips
- https://stainsfile.info/stain/metallic/gomori.htm
- Gray, Peter. (1954). The Microtomist’s Formulary and Guide. Originally published by: – The Blakiston Co.Republished by:– Robert E. Krieger Publishing Co.
- Drury, R A, and Wallington, E A,(1967). Carleton’s histological technique., Ed. 5.
Oxford University Press, London, England. - Hayashi, I., Tome, Y. and Shimosato, Y.,(1989) Thiosemicarbazide used after periodic acid makes methenamine silver staining of renal glomerular basement membranes faster and cleaner. Stain Technology, v 64, p 185.
